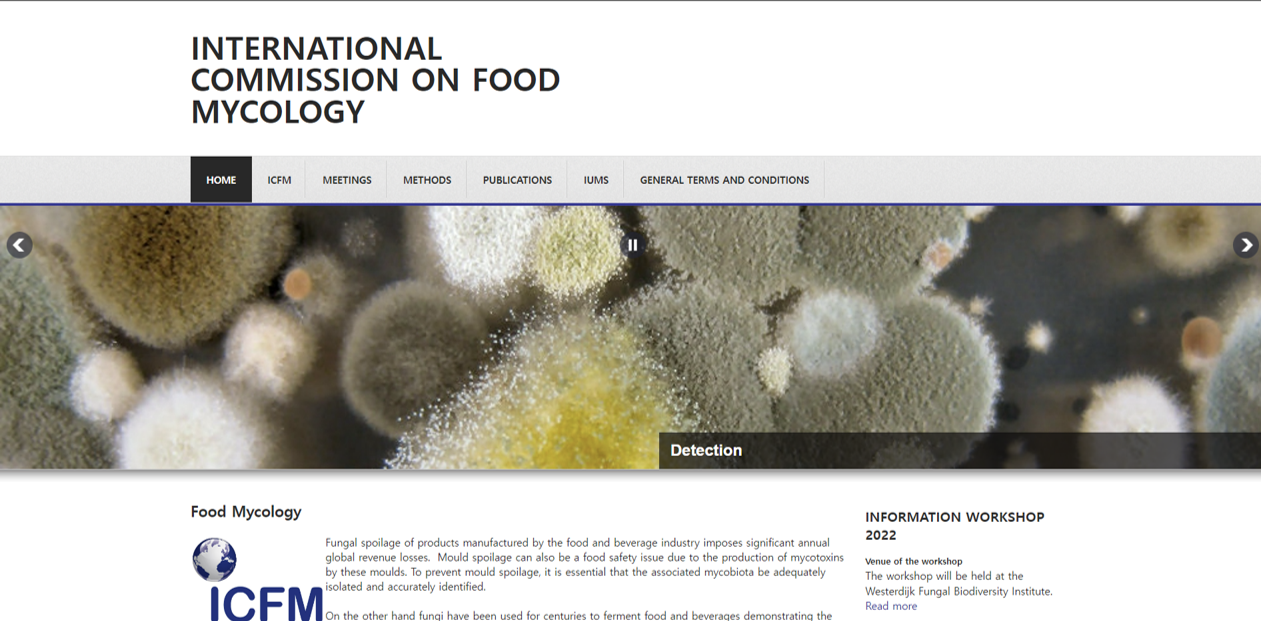
ICFM homepage.png

식품곰팡이–분류, 부패 그리고 독소
[2022 식품곰팡이국제위원회(ICFM) 워크숍]
식품에는 곰팡이가 핀다. 살아 있지 않은 생명체는 흙으로 돌아가야 다시 새로운 생명을 잉태하기에 생태학적으로 지극히 당연한 일이다.
그런데 음식을 보관하면서 먹어야하는 사람의 입장에서 곰팡이는 골칫거리다. 그나마 일반인은 음식에 곰팡이가 피면 아까워도 버리면 그만이지만 식품회사의 경우에는 상황이 다르다. 슈퍼마켙에서 파는 과자에 곰팡이가 피었다면, 환불은 말할 것도 없고, SNS가 발달한 요즘에는 난리가 난다. 곰팡이 핀 과자는 회사의 존립을 위협할 만큼 큰 문제다.
이렇게 식품의 곰팡이가 중요하니 이를 연구하는 학자들이 있을 것이고, 학자들이 있으면 지식을 교류하고 협력하는 모임이 있을 것이다. 국제식품곰팡이위원회(International commission on Food Mycology, ICFM).
국제식품곰팡이위원회 홈페이지
국제식품곰팡이위원회 홈페이지이 위원회는 매 3년마다 워크숍을 열어서 식품 곰팡이 분야의 그간의 발전상황을 공유하고 협력한다. 그 위원회가 지난 7월 17일부터 19일까지 3일간 열렸다. 워크숍의 정식 제목은 “2022 ICPA/ICFM 워크숍, 식품곰팡이 – 분류, 부패 그리고 독소”이다.
코로나19의 만연 중에 어렵게 참가하였기에 그 내용을 공유하고자 한다.
ICFM 2022 개요
워크숍은 네덜란드의 곰팡이다양성연구소(Westerdijk Fungal Biodiversity Institute, WI)에서 열렸다. WI는 1904년에 설립되어 10만여 균주의 곰팡이를 보존하고 있는 자타공인 세계 최고의 곰팡이 자원센터이다.
 세계 최대 곰팡이 자원센터, Westerdijk Institute
세계 최대 곰팡이 자원센터, Westerdijk Institute이번 워크숍의 WI 개최는 IUMS(세계미생물학회연합) 2022 학술대회와 연관된다. ICFM은 IUMS의 산하 위원회인데 IUMS가 2022년 학술대회를 네덜란드의 로테르담에서 개최함에 따라 사전행사 격으로 워크숍이 계획된 것이다.
그렇다고 해서 ICFM 워크숍의 WI 개최가 부족하다는 의미는 결코 아니다. ICFM 위원은 16명이지만 이번 워크숍에는 현장에 50명, 온라인으로 16명해서 모두 66명이 참석하였다. 학회 발표 장소는 WI 지하1층의 120석 규모의 강당을 사용하였고, 점심식사와 커피타임은 1층의 식당을 사용하였는데, 특히 강당은 참가 규모에 걸맞아 집중력을 높일 수 있었다.
 간식과 점심식사를 제공한 카페테리아
간식과 점심식사를 제공한 카페테리아
이번 워크숍에서 식사와 주거는 매우 만족도가 높았다. 먼저 주거는 주최측에서 WI에 가까운 호텔(Van der Valk Hotel de Bilt)을 지정하고 참가자들에게 이 호텔을 사용할 것을 제안하였다. 이 호텔에서 워크숍 전날(16일)과 첫날의 만찬을 하였다. 특히 워크숍 전일 만찬은 처음이라 서로 서먹할 수 있는 분위기를 화기애애하게 하는 데 큰 도움을 주었다. 워크숍 마지막 만찬은(18일) 네덜란드 특유의 운하 옆의 벙크 레스토랑에서 하였는데 참석자들에게 유트레크드에 대한 좋은 추억을 주었다. 워크숍에서 학문적인 측면도 중요하지만 사교와 인간적인 네크워크를 중요시하는 유럽인들의 시각을 읽을 수 있었다.
 워크숍 전일 만찬, 워크숍 3일간 매일 만찬 회식이 있었다.
워크숍 전일 만찬, 워크숍 3일간 매일 만찬 회식이 있었다.
워크숍은 식품곰팡이의 생리, 생태, 군집, 분류, 제어, 발효식품, 방법론의 7개 쎄션에서 40명의 발표가 있었다.
ICFM 2022 학술 발표 내용
워크숍은 ICFM의 거목이었던, 지난 2월에 타계한 John Pitt에 대한 추모로 시작하였다. 그는 CSIRO (호주연방과학산업연구기구)의 기술원으로 시작하여 호주의 대표적인 균학자가 되었으며 특히 Robert Samson과 함께 Penicillium과 Aspergillus의 분류를 이끌었다. 그의 저서 Fungi and Food Spoilage (곰팡이와 식품 부패), The genus Penicillium and its teleomorphic states Eupenicillium and Talaromyces는 이 분야의 학자라면 한권씩 가지고 있는 책들이다. 내 책꽂이에도 두권의 책이 꽂혀 있고 Fungi and food spoilage는 지금도 자주 활용한다.
Emilia Rico, Su-lin Heden, Marta Taniwaki 등이 추모발표를 하였는데 특히 Su-lin은 청중들이 직접 핸드폰으로 John Pitt를 추억할 수 있게 하였다. 아래 그림은 John Pitt 하면 연상되는 단어들을 워크숍에 참석자들이 직접 3개씩 입력한 것이다. 역시 John은 Penicillium 연구의 큰 업적을 남긴 것으로 기억되었다.
 John Pitt 하면 연상되는 단어 3개를 쓰세요.
John Pitt 하면 연상되는 단어 3개를 쓰세요.
Session 1. Developments in Methodology
첫 번째 쎄션은 식품곰팡이 방법론이었다. 먼저 Emilia Rico의 곰팡이와 효모의 ISO (국제표준기구) 표준 계수법에 대한 최근 동향 보고가 있었다. 2008년도에 DRBC 배지를 기준으로하여 수분활성도 0.95 이상과 미만으로 표준계수법을 정하였으나, 하나의 규정으로 합치는 작업을 하고 있으며 배지도 다양한 배지를 재료에 따라 다르게 사용하는 것을 검토하고 있다는 것이었다. 그리고 곰팡이의 meta-barcoding에 대하여 DSMZ 곰팡이 큐레이터인 Christiane Baschien의 발표가 있었다. 실내공기 등의 여러 환경에서 meta-barcoidng에 의한 곰팡이 상(flora) 조사가 이루어졌으나 주로 사용하는 DNA 영역인 rDNA- ITS의 해상력 부족과 데이터 부족으로 아직 많은 한계를 보인다고 설명하였다.
 곰팡이와 효모 계수의 ISO 규정 동향 (Emilia Rico, 미국)
곰팡이와 효모 계수의 ISO 규정 동향 (Emilia Rico, 미국)
2. Fungal communities and Ecology
두번째 쎄션은 식품곰팡이 군집과 생태였다. 식물병원균, 드라이에이징 소고기, 카사바의 미생물 상(flora)에 대한 발표가 있었다. 특히 드라이에이징 소고기에서 Mucor를 포함한 털곰팡이과(Mucoraceae)의 곰팡이가 중요한 역할을 한다는 부분과, 이들의 연구를 한국의 김용훈, 오상남 교수의 한우 실험의 결과와 비교 고찰하는 것이 흥미로웠다. 브라질의 Taniwaki 박사는 카사바의 곰팡이 상(flora)을 발표하였는데 노란아스페곰팡이(Aspergillus flavus)가 우점함에도 아플라톡신 생성은 없었다는 부분이 특이하였다.
 드라이에이징의 곰팡이 연구. 한국의 한우 실험 논문이 인용되어 흥미로웠다(Grzegorz ostrowski, 폴란드).
드라이에이징의 곰팡이 연구. 한국의 한우 실험 논문이 인용되어 흥미로웠다(Grzegorz ostrowski, 폴란드).또한 흥미로운 것이 Naresh 교수의 고춧가루에서 노란아스페곰팡이(A. flavus)와 아플라톡신의 생태와 제어에 관한 발표였다. 고춧가루는 수분활성도 0.9이상, 온도 25-30℃가 아플라톡신 생성의 최적 조건이라는 것이다. 그리고 아플라톡신 생성을 막기 위한 식품보존제는 Sodium metabisulfate (NaMBS)가 가장 효과적이라고 하였다. 고춧가루가 한국 음식의 주요 재료이기에 Naresh 교수에게 한국인 대상 웹세미나를 제안하였고 흔쾌히 수락해 주었다.
 고춧가루의 아플라톡신 저감화 연구, 한국인들에게 많은 도움이 될 것 같다 (Naresh Magan, UK).
고춧가루의 아플라톡신 저감화 연구, 한국인들에게 많은 도움이 될 것 같다 (Naresh Magan, UK).
3. Mycotoxins
세 번째 쎄션은 최근 중요도가 증가하고 있고 일반인도 관심이 많은 곰팡이독소였다. 먼저 아시아에서 밀과 보리에 발생하여 deoxynivalenol과 zearalenone을 생산하는 Fusarium asiaticum에 대한 유전체 연구와 이 곰팡이와 독소의 생성 적정 조건에 대한 발표가 있었다. 이들은 기후변화로 인하여 중국을 포함한 아시아 지역에 이 독소가 더욱 문제가 되고 주의를 요한다고 주장하였다.
곰팡이독소하면 빠져서는 안되는 아플라톡신에 대한 2건의 보고가 있었다. 독일의 Schmidt-Heydt 박사는 케냐, 나이지리아 등의 사하라 남부 국가들의 아플라톡신 문제해결을 위한 AflaZ (Zero aflatoxin) 프로젝트에 대하여 설명하였다. 독일연구소와 아프리카 국가들이 함께 하여 옥수수의 재배와 보관을 개선하고, 또한 실험적으로는 옥수수에 청색광을 조사하고, Trichoderma afroharzianum에 의한 생물적 방제로, 옥수수 보존 시에 아플라톡신 생성 곰팡이의 생장을 억제할 수 있었다고 하였다. 이어서 아르헨티나에서는 옥수수의 아플라톡신 생성 억제를 위하여 재배 시에 비독소 생성 균주의 사용과, 보존 시에 밀폐형 사일로 백의 활용 등으로 아플라톡신을 저감할 수 있었다고 보고하였다.
 독일의 아프리카 지역의 아플라톡신 제로 연구 및 활동 소개 (Markus Schmidt-Heydt, 독일)
독일의 아프리카 지역의 아플라톡신 제로 연구 및 활동 소개 (Markus Schmidt-Heydt, 독일)또한 흥미로운 발표는 덴마크의 Jens Frisvad의 곰팡이 독소로서 3BNP (3-Nitropropionic acid)의 위험성에 대한 보고이다. 이 독소는 사탕수수와 코코넛 열매에 생성되어 사람을 죽음에까지 이르게 하였는데, 아직도 이에 대한 정밀한 조사와 규제가 없다는 것이다. 특히 노란아스페곰팡이(A. flavus)가 3BNP를 많이 생산하므로, 산업용으로 쓰이는 노란누룩곰팡이(황국균, A. oryzae)도 이를 생산할 가능성이 높으므로 주시할 필요성이 있다고 하였다. 황국균을 많이 사용하는 우리나라를 포함한 일본 등에서 이 독소에 대하여 관심을 가져야겠다.
그 외에 Endang 교수는 인도네시아의 곰팡이독소 관련 규정과 관리에 대하여 발표하였는데 규정은 엄격하나, 시행이 잘 되지 않아 인도네시아의 곰팡이 독소 관리에 문제가 있다고 하였다.
Schmidt-Heydt 박사의 강의는 실제 들을 때에는 큰 관심을 두지 않았는데, 만찬 시에 자리를 함께 하여 많은 이야기를 하다 보니 새로이 관심을 가지고 자세히 보게 된 것이다. 학문을 함에 있어 사람을 아는 것이 얼마나 중요한지를 보여 주는 단적인 예라 할 수 있다.
4. Taxonomy of food-borne fungi
4번째 쎄션은 식품곰팡이 분류로서 개인적으로 가장 관심이 큰 분야다. 이 워크숍이 ICPA (Internaitonal commission on Penicillium and Aspergillus)와 공동으로 열리는 만큼 식품에 큰 영향을 미치는 Penicillium과 Aspergillus (P&A)의 분류가 주로 다루어졌다.
먼저 Robert Samson은 John Pitt를 추억하면서, 1985, 1989, 1997년의 3차례 P&A 워크숍에서 함께 두 속의 분류체계를 확립하고 현재명을 정리하였으나, 2012년 ICPA 미팅에서는 일균일명 체계를 맞이하여 Aspergillus에서 서로 다른 의견으로 대립하여 아쉬웠다고 이야기하였다. 이어 Jens Frisvad는 다양한 대사산물의 생성 여부가 P&A 속의 종과 일치하므로 화학적 분류의 중요성을 강조하였다. Jos Houbraken은 P&A에서 종이 지나치게 세분화되어 다루기 불편한 부분이 있으므로 section, series 등의 속하계급(Infraspecific rank)의 중요성을 언급하였다. 속하계급이 이들 곰팡이의 생리적 특성과 생장 위치를 잘 대변한다는 것이다. Frantisek Sklenar는 새로운 종분계법(species delimitation method)을 이용하여 Aspergillus의 종을 재분류하였는데, 기존에 17종이 보고된 Aspergillus series Versicolors의 경우에 종분계법에 의하여 4종으로 재정립하였다. Frantisek의 주장은 아직 학계에서 널리 인정되고 있지는 않지만, DNA 염기서열 분석에 의하여 지나치게 세분화되고 있는 현재 곰팡이 분류체계에 대한 반대의 움직임으로, 향후 추이가 주목된다.
 DNA 염기서열 분석으로 신종이 가파르게 증가하는 추세에서 더 이상 종을 많이 만들지 말고 합치자는 주장이 매우 흥미로웠다(Frantisek Sklenar, 체코).
DNA 염기서열 분석으로 신종이 가파르게 증가하는 추세에서 더 이상 종을 많이 만들지 말고 합치자는 주장이 매우 흥미로웠다(Frantisek Sklenar, 체코).일반적으로 식물병원균으로 분류되는 Fusarium에 대한 발표도 2건이나 있었다. Aspergillus 속을 다수의 속으로 나눌 것인지 아니면 하나의 속으로 유지할 것인지가 균학계의 큰 논쟁거리였는데 현재는 하나의 속을 유지하는 쪽으로 정리되었다. 하지만 Fusarium의 경우는 속을 나눌것인지 유지할 것인지가 한창 논쟁 중이다. 유럽쪽은 나누자는 편이고 미국쪽은 유지하자는 쪽인데 발표자 Pedro Crous는 나누자는 쪽의 대표 학자이다. Crous는 분자적 특징뿐만이 아니라 유성세대, 형태적 특징, 생리적 특징 등에서 Fusarium은 속을 나누는 것이 타당하다는 주장을 하였다. 프랑스의 Monika Cotton은 치즈에서 매우 중요한 역할을 하는 과거에 Fusarium에 속하였던 Bisifusarium domesticum, Longinectira lagenoides 등에 대한 단백질과 지방 분해와 향기물질 생성에 대하여 발표하였다. 일반적으로 치즈 하면 Penicillium인데 Fusarium이 치즈에서 중요한 역할을 한다니 식품으로 사용되는 Fusarium venenatum 등과 함께 Fusarium의 역할에 대하여 흥미를 자아내었다.
 Fusarium을 두고 미국과 유럽이 전쟁이다. Fusarium을 여러속으로 나누자는 대표적인 유럽 학자 Pedro Crous (네덜란드) 강의
Fusarium을 두고 미국과 유럽이 전쟁이다. Fusarium을 여러속으로 나누자는 대표적인 유럽 학자 Pedro Crous (네덜란드) 강의Session 5. Biocontrol and processing
다섯 번째는 식품 가공 시의 곰팡이의 제어에 관한 내용이다. 가공 시에 곰팡이를 제어하는 데 열처리가 가장 기본적인 방법이지만 여러 가지 한계가 있으므로 이를 대체하는 오존, 고정수압(high hydrostatic pressure, HHP), 저온플라즈마(cold plasma), 펄스전기장(Pulsed electric field), 전해산화수(Electrolysed oxidising water) 등의 적용 결과를 발표하였다. 또한 유제품 가공 시에 살균제로 사용하는 에탄올, 차아염소산나트륨, 과산화수소는 환경과 곰팡이 종류에 따라 그 효과가 매우 차이가 난다는 보고도 있었다. 이 세션은 익숙하지 않은 분야라 충분히 이해할 수 없었기에 발표제목을 열거하는 것으로 갈음하고자 한다.
 식품의 25%가 미생물의 부패에 의하여 버려진다. 이를 어떻게 막을 것인가 (Masja Groot, Netherlands)?
식품의 25%가 미생물의 부패에 의하여 버려진다. 이를 어떻게 막을 것인가 (Masja Groot, Netherlands)?- Effect of gaseous ozone and ozonized water against food-spoiling filamentous fungi on stainless steel (식품 부패 곰팡이에 오존 및 오존수 처리 효과)
- Impact of (mild) processing on food spoilage fungi [식품 부패 곰팡이의 가벼운처리 (열처리 외의 물리적 처리)의 영향]
- Studies on the efficacy of electrolysed oxidising water to control Aspergillus carbonarius and ochratoxin A contamination on grape (포도에 Aspergillus carbonarius 및 ochratoxin A 오염을 제어하기 위한 전해산화수의 효능에 관한 연구)
- Non-ochratoxigenic black aspergilli as biological control agents (생물학적 방제제로서 오크라톡신 비생성 검은 아스페곰팡이)
- Effect of ozone treatment of different commodities: relative control of germination, growth and mycotoxin production by Aspergillus and Fusarium species (다양한 상품의 오존 처리 효과: Aspergillus와 Fusarium 종의 발아, 성장 및 진균독 생산의 제어)
- Biotic and abiotic factors impact the efficacy of antifungal biocides used in the dairy industry (생물학적 및 비생물적 요인은 유제품 생산 시에 사용되는 살균제의 효능에 영향을 미친다.)
 사람은 열처리, 낮은 수분활성도, 낮은 pH, 저온보관, 보존제 등을 이용하여 곰팡이 생장을 억제하고자 하며, 곰팡이는 이런 어려움을 극복하고 생장하고자 한다(Brule,네덜란드)
사람은 열처리, 낮은 수분활성도, 낮은 pH, 저온보관, 보존제 등을 이용하여 곰팡이 생장을 억제하고자 하며, 곰팡이는 이런 어려움을 극복하고 생장하고자 한다(Brule,네덜란드)
Session 6 Food fermentation
발효 쎄션은 주로 식품 부패 곰팡이의 군집, 생리, 독소, 제어를 다루는 ICFM 입장에서 보면 특별한 쎄션이다. 동양에서 참석한 우리를 위한 배려로 느껴졌다. 이 세션은 동양의 대표적인 발효 식품인 장류 제조와 연관된 Aspergillus와 관련하여 3개 발표, 서양의 대표적인 발효식품인 치즈와 연관된 Penicillium에 관련하여 2개 발표로 구성되었다.
먼저 저자는 메주의 곰팡이 상(flora)과 주요 메주 곰팡이의 역할에 대하여 그리고 메주의 주요 곰팡이인 Penicillium의 깊은맛 생성물질에 대하여 발표하였다. 서양의 학자들은 자연발생적으로 핀 메주곰팡이에 대하여, 또한 서양의 대표적 발효식품 동물성 치즈에 주요 곰팡이가, 동양의 식물성 콩발효물에서도 중요한 역할을 한다는데 큰 흥미를 보였다.
한갑훈 교수는 메주에서 선발한 황국균 등의 종균 곰팡이를 이용한 메주발효에 대하여 강의를 준비하였으나 상(喪)을 당하는 바람에 발표도 하지 못하고 귀국하여야 하는 안타까운 일이 있었다. 이탈리아 아래, 말타에서 온 Vasilis Valdramidis는 쌀에서 황국균의 적정 생장 조건과 이에 따른 향미 관련 유전자의 발현에 대하여 발표하였는데, 왜 유럽의 작은 섬나라 말타에서 황국균에 대한 쌀 발효를 연구하는지 궁금하였다.
Penicillium 연구는 먼저 이탈리아 식품생산과학연구소의 Giancarlo Perrone가 이탈리아의 치즈, 살라미와 빵, 올리브, 밀 등에서 분리한 Penicillium 26균주의 유전체 연구를 발표하였다. 그리고 프랑스의 Brest 대학의, Emmanuel Coton 그룹은 유전체 분석에 의하여 구분된 Penicillium roqueforti 곰팡이의 5개 유전집단[치즈 유래 3집단(Roqueforti, Terminnon, 기타 치즈분리 곰팡이)과 그 외 2 집단(목재, 사일리지 유래)]에 대한 다양한 조건에서 생장 차이, 대사물질의 차이 등에 대하여 보고하였다. 치즈에서 유래하지 않은 곰팡이 유전집단이 더 다양한 2차 대사산물을 생산하였고, 치즈에서 유래한 기타 치즈분리 곰팡이 집단은 곰팡이독소(mycophenolic acid)를 생산하는 유전자 mpaC가 결여되어 있어 이를 생산하지 않았다.
 곰팡이를 식품오염균으로 보는 유럽인에게 치즈를 만드는 Pen. roqueforti는 흥미로운 대상이다. 유전체 분석으로 5개 집단으로 구분하고 특성을 분석하였다(Crequer).
곰팡이를 식품오염균으로 보는 유럽인에게 치즈를 만드는 Pen. roqueforti는 흥미로운 대상이다. 유전체 분석으로 5개 집단으로 구분하고 특성을 분석하였다(Crequer).Session 7. Physiology of food spoilage fungi
마지막 세션은 식품 부패곰팡이의 생리였다. 오염의 시초가 되는 곰팡이 포자의 발아를 시작으로 하여 보존제로 주로 사용되는 소르브산(sorbic acid)에 저항성을 나타내는 곰팡이와 이들의 기작 등이 발표되었다. 발표내용은 발표 제목으로 갈음한다.
 곰팡이 포자를 이해하는 것이 식품 부패를 막는 첫걸음이다. WI에서 곰팡이의 다양한 전자현미경 사진을 찍는 Dijksterhuis가 곰팡이 포자 발아에 대하여 설명하고 있다.
곰팡이 포자를 이해하는 것이 식품 부패를 막는 첫걸음이다. WI에서 곰팡이의 다양한 전자현미경 사진을 찍는 Dijksterhuis가 곰팡이 포자 발아에 대하여 설명하고 있다.- The fungal spore: tales of beginnings (곰팡이 포자: 이야기의 시작)
- Intraspecific variability in conidial heat resistance of food spoilage fungi (식품 부패 곰팡이의 분생포자 내열성의 종내 균주간 차이)
- The interactions among isolates of Lactiplantibacillus plantarum and dairy yeast contaminants: towards biocontrol applications (L. plantarum 균주와 유제품 오염 효모와의 상호관계: 생물제어 응용 분야에서)
- Natural variation and the role of Zn2Cys6 transcription factors SdrA, WarA and WarB in sorbic acid resistance of Aspergillus niger (A. niger의 보존재 소르브산 저항성에서 자연적 변이와 Zn2Cys6 전사인자 SdrA, WarA, WarB의 역할)
- High sorbic acid resistance of Penicillium roqueforti is mediated by the SORBUS gene cluster (P. roqueforti의 높은 소르브산 저항성은 SORBUS 유전자 클러스터와 연관된다.)
- Preservative resistance of spoilage yeasts at low glucose and relevance for reduced-sugar formulations (저포도당 음료에서 부패 효모의 보존제 저항성 및 당 비율에 따른 효모의 보존제 저항성)
Inoculum size matters: relationship between preservative MIC and heteroresistance in spoilage yeasts (접종량 문제: 부패 효모에서 방부제 MIC와 이종 저항성 사이의 관계)
ICFM 워크숍과 한국의 식품곰팡이 연구
이상으로 국제식품곰팡이위원회의 2022 워크숍, “식품균학 - 분류, 부패 그리고 곰팡이독소”의 보고를 마친다. 지식의 부족, 시간의 부족, 그리고 지면의 부족으로 충분하게 기술하지는 못하였지만 그래도 국내에서는 생소한 이 분야에 대한 소개 역할은 하지 않았나 생각한다.
서문에서 언급한 바와 같이 식품의 곰팡이는 산업적으로 매우 중요하다. 하지만 한국에서는 이 분야 연구가 매우 부족하다. 곰팡이독소, 발효 곰팡이, 저장곡물 부패 곰팡이 정도가 그나마 한국에서 이루어지는 이 분야 연구다. 물론 그 외의 식품곰팡이 연구도 있겠지만 단편적인 연구에 그치는 것으로 판단된다.
이에 비해 국제식품곰팡이위원회에서는 식품곰팡이의 생리, 군집, 분류, 곰팡이독소, 제어, 방법론 등 전체 분야를 다루고 있다. 이러한 측면에서 우리나라에서도 산재되어 있는 식품곰팡이 연구를 연계하고 연구자들이 서로 교류할 무대를 만들 필요성이 있겠다. 이에 한국균학회 산하에 또는 식품과학회 산하에 식품곰팡이 그룹을 만들고 협력하는 것도 좋은 방법이 되겠다.
때마침 저자는 국제식품곰팡이위원회의 위원으로 임명되었다. 식품곰팡이 분야의 국제 동향을 한국에 전달하고, 한국의 식품곰팡이 분야의 애로사항을 함께 고민하여 해결할 수 있도록 노력해야겠다는 다짐을 해본다.
 ICFM 전임회장 독일의 Ludwig Nielson이, 신임회장 네덜란드 Jos Houbraken에게 의사봉을 전달했다. 주는 사람이나 받는 사람이나 별로 양반 같지는 않다^-^.
ICFM 전임회장 독일의 Ludwig Nielson이, 신임회장 네덜란드 Jos Houbraken에게 의사봉을 전달했다. 주는 사람이나 받는 사람이나 별로 양반 같지는 않다^-^. 2022 ICFM 워크숍 참석자, 대면 참석 50명, 비대면 참석 16명으로 알찬 소규모 전문가 워크숍이었다.
2022 ICFM 워크숍 참석자, 대면 참석 50명, 비대면 참석 16명으로 알찬 소규모 전문가 워크숍이었다.붙임. 2022 ICFM workshop 초록집(https://www.foodmycology.org/images/download/Abstract_book_ICFM_2022.pdf).
2022. 08. 09. ICFM 워크숍을 다녀와서.